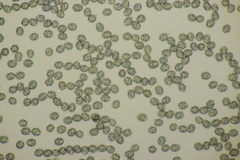
Lactarius pallidus
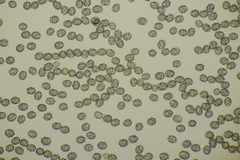
Lactarius pallidus

Lactarius pallidus: taxon details and analytics
- Domain
- Kingdom
- Fungi
- Phylum
- Basidiomycota
- Class
- Agaricomycetes
- Order
- Russulales
- Family
- Russulaceae
- Genus
- Lactarius
- Species
- Lactarius pallidus
- Scientific Name
- Lactarius pallidus
Summary description from Wikipedia:
Lactarius pallidus in languages:
- Bokmål
- blekriske
- Czech
- ryzec bledý
- Danish
- Bleg mælkehat
- Dutch
- Bleke melkzwam
- English
- Pale Milkcap
- Estonian
- pöögiriisikas
- French
- Lactaire pâle
- Hungarian
- Fakó tejelőgomba
- Lithuanian
- Blyškusis piengrybis
- Swedish
- blekriska
Images from inaturalist.org observations:
We recommend you sign up for this excellent, free service.
Parent Taxon
Sibling Taxa
- Deliciosi
- Lactarius acerrimus
- Lactarius aestivus
- Lactarius albocarneus
- Lactarius alnicola
- Lactarius aspideus
- Lactarius atroviridis
- Lactarius blennius
- Lactarius caespitosus
- Lactarius cinereus
- Lactarius circellatus
- Lactarius controversus
- Lactarius crassus
- Lactarius dryadophilus
- Lactarius evosmus
- Lactarius flavidus
- Lactarius flavopalustris
- Lactarius fluens
- Lactarius glyciosmus
- Lactarius hysginoides
- Lactarius hysginus
- Lactarius ilicis
- Lactarius illyricus
- Lactarius kauffmanii
- Lactarius lepidotus
- Lactarius lilacinus
- Lactarius liyuanus
- Lactarius mairei
- Lactarius mammosus
- Lactarius mexicanus
- Lactarius montanus
- Lactarius musteus
- Lactarius olivaceoumbrinus
- Lactarius olympianus
- Lactarius pallidus
- Lactarius peckii
- Lactarius pilatii
- Lactarius pseudomucidus
- Lactarius pubescens
- Lactarius repraesentaneus
- Lactarius resimus
- Lactarius rubriviridis
- Lactarius salicis-reticulatae
- Lactarius scoticus
- Lactarius spinosulus
- Lactarius splendens
- Lactarius tesquorum
- Lactarius torminosus
- Lactarius trivialis
- Lactarius tuomikoskii
- Lactarius turpis
- Lactarius umerensis
- Lactarius utilis
- Lactarius vietus
- Lactarius yazooensis
- Lactarius zonarius
- Pyrogalini
- Scrobiculati
- Uvidi